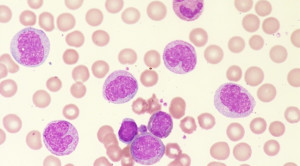

Light Exposure at Night and Cardiovascular Disease Incidence Windred DP, Burns AC, Rutter MK, et al. JAMA Network Open. 2025. 8(10):e2539031. doi:...(Baca Selengkapnya)
Artikel Terkait
-

-
 Efek Durasi dan Intensitas Menyusui terhadap Risiko Penyakit Jantung Koroner dan Stroke pada Ibu – Telaah Jurnal Alomedika
Efek Durasi dan Intensitas Menyusui terhadap Risiko Penyakit Jantung Koroner dan Stroke pada Ibu – Telaah Jurnal AlomedikaDuration and Intensity Of Lactation And Maternal Risk Of Subsequent Incident Coronary Artery Disease and Stroke—A Prospective Cohort Study Christensen SH, Aarestrup...(Baca Selengkapnya)
-

-

-
-

-

-

-

-







